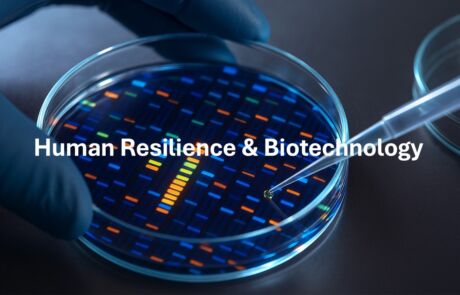
Human Resilience & Biotechnology Human Resilience & Biotechnology

Os Challenges do DIANA para 2026 já foram lançados, desafiando todos os inovadores que estejam interessados em desenvolver tecnologias disruptivas nas 10 áreas prioritárias para este ano.
Clique nas imagens para consultar os desafios.

A idD Portugal Defence é a entidade responsável pela implementação do Acelerador que Portugal irá acolher no âmbito da iniciativa DIANA promovida pela NATO para apoiar o empreendedorismo de base tecnológica associado à Defesa.
Adicionalmente, Portugal é subscritor do NATO Innovation Fund, um fundo que irá investir em start-ups que desenvolvam deep tech com duplo uso numa fase early-stage e que complementa as atividades do DIANA.
Publicações relacionadas
Webinar sobre os novos desafios NATO DIANA
A idD Portugal Defence e o Instituto Pedro Nunes organizaram, durante a manhã de hoje, um webinar informativo sobre os novos desafios lançados pelo NATO DIANA, com o objetivo de apoiar entidades portuguesas no processo de candidatura à edição de 2026.
NATO DIANA seleciona portuguesa ThothX Meridian
A ThothX Meridian, uma empresa portuguesa especializada em Space Domain Awareness (SDA), foi selecionada para os Challenges 2024 do NATO Defence Innovation Accelerator for the North Atlantic (DIANA), destacando-se entre mais de 2.600 candidaturas.
idD apresenta ecossistema de inovação à NATO
A idD Portugal Defence, em colaboração com a Direção-Geral de Recursos da Defesa Nacional (DGRDN), organizou no dia 24 de setembro, duas sessões dirigidas às equipas de coordenação do Defence Innovation Accelerator for the North Atlantic (DIANA) da NATO e do NATO Innovation Fund (NIF) sobre o ecossistema de inovação em Portugal.
Pitch For NATO
A idD Portugal Defence, em parceria com a Direção-Geral de Recursos da Defesa Nacional, está a organizar um pitch para que 8 start-ups possam apresentar-se às equipas da NATO, onde poderão ter acesso a apoios de 100.000€ (não dilutivo), mentoria e acesso a uma rede de 180+ centros de teste através do DIANA e a capital de risco através do NIF.
NATO / DIANA Info Session: Oportunidades de financiamento para start-ups e PMEs
Apresentar os novos instrumentos de financiamento e as oportunidades da NATO para inovadores com soluções deep-tech de duplo uso (civil e militar) com capacidade para responder a desafios críticos de segurança e defesa nas áreas da Resiliência Energética, da Partilha Segura de Informação e da Deteção e Vigilância. É este o objetivo da Sessão de Informação que decorrerá a 30/junho em Aveiro
NATO define áreas prioritárias para a Inovação em 2023
Resiliência energética, partilha segura de informação e deteção e vigilância são as três áreas prioritárias que guiarão o trabalho em inovação da NATO, em 2023, no âmbito das tecnologias emergentes e disruptivas!
Página atualizada no dia 11/07/2025